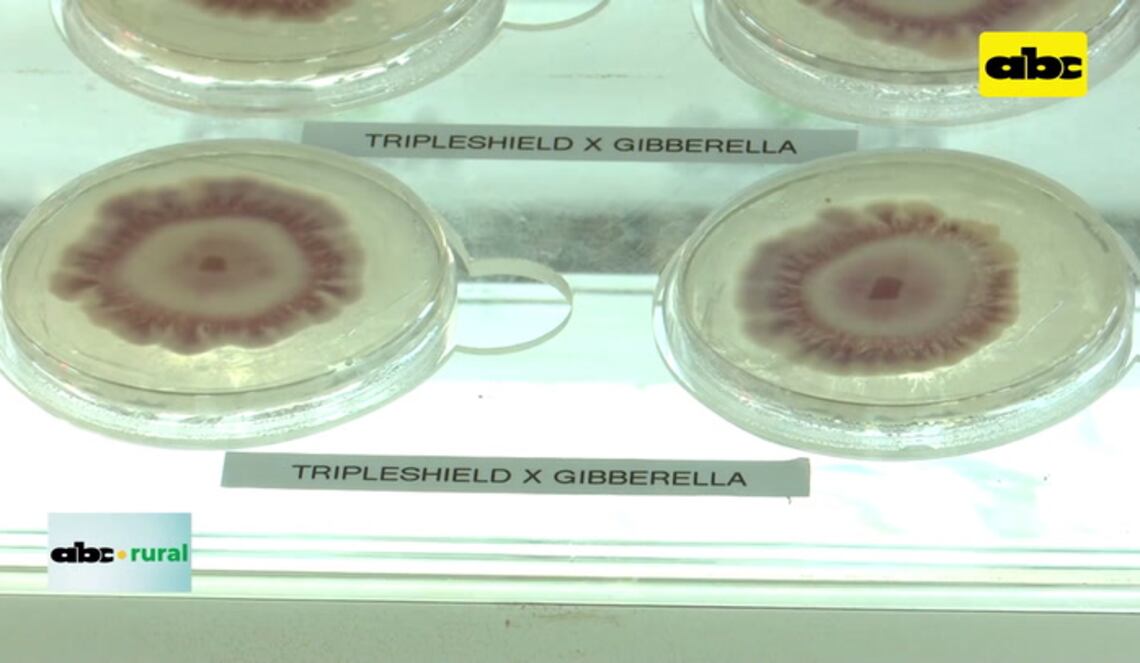
Background ABCTV JWP

4 de noviembre de 2025
- Juegos
- Últimas Noticias
- BeneficiosNuevo
- Nacionales
- Secciones ABC en el EsteChaco
- Policiales
- Deportes
- Economía
- Política
- Mundo
- Espectáculos
- Gente
- Sociales
- Editorial y Opinión
- Secciones TapaEditoriales de ABC ColorOpiniónCartas a la directora
- Edición Impresa LocalesInvestigaciones
- Servicios
- Temas de interés
- Suplementos
- Multimedia
- Negocios & comerciales
- Canales
- Suscripciones ABC
- Secciones EDICIÓN IMPRESAABC DIGITALABC ePaper
- ePaper
- ABC Revista
36º
Ahora
HOY
Min
18º
Máx
36º
undefined 2025-11-05
Min
21º
Máx
29º
undefined 2025-11-06
Min
19º
Máx
31º
undefined 2025-11-07
Min
17º
Máx
35º
undefined 2025-11-08
Min
14º
Máx
23º
undefined 2025-11-09
Min
13º
Máx
28º
Cotizaciones del día
DOLAR
Compra
6.900
Venta
7.200
PESO
Compra
1
Venta
10
REAL
Compra
1.270
Venta
1.390
EURO
Compra
7.900
Venta
8.700
YEN
Compra
45
Venta
60
PESO URUGUAYO
Compra
160
Venta
220
11 de julio de 2023









